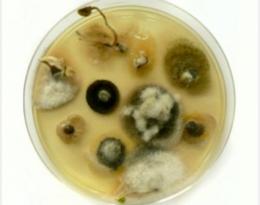

Virulence des champignons phytopathogènes : cas d'Alternaria brassicicola
Cultures légumières
Légumes feuilles - Choux
Cultures tropicales
Légumes tropicaux
Grandes cultures / Polyculture-élevage
Colza
Année de publication
(mis à jour le 08 fév 2021)
Source : Site INRAE
Réferences :
Publié le 11 mai 2020
Certains champignons sont capables d’infecter et de tuer leur plante hôte. De nombreux facteurs influent sur le caractère pathogène de ces champignons. Alternaria brassicicola est non seulement capable infecter les feuilles de son hôte, mais aussi de se transmettre à ses graines, contaminant ainsi les générations suivantes.
Le point sur la recherche :
- Rôle de microdomaines membranaires dans la virulence des champignons phytopathogènes
- Comment le champignon Alternaria s’adapte à la phase de dessiccation des semences ?
- Transmission d’agents phytopathogènes à la semence